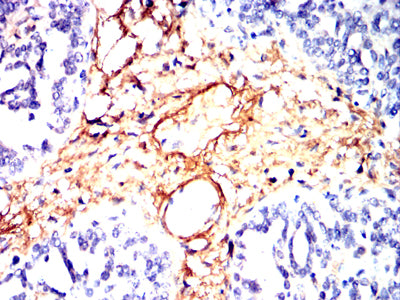

电话:18013895086
电话:025-68037686
地址:江苏生命科技创新园F6幢1层
订购:nanjing03@biogot.com
服务:biorase01@biogot.com
合作:lvyun@biogot.com
支持:may@biogot.com
电话:18013895086
电话:025-68037686
地址:江苏生命科技创新园F6幢1层
订购:nanjing03@biogot.com
服务:biorase01@biogot.com
合作:lvyun@biogot.com
支持:may@biogot.com

电话:18013895086
地址:江苏生命科技创新园F6幢1层